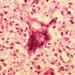
Sarampo atinge o nível mais elevado de casos na Europa em mais de 25 anos

Na última quinta-feira, o presidente dos Estados Unidos, Donald Trump, mais uma vez causou polêmica ao afirmar que a anexação da Gronelândia pelo seu país é inevitável e que isso seria benéfico para a segurança internacional. A declaração foi feita durante uma coletiva de imprensa na Casa Branca, gerando reações diversas ao redor do mundo.
A Gronelândia é uma ilha localizada no Oceano Ártico, pertencente ao Reino da Dinamarca. Com uma área de mais de 2 milhões de quilômetros quadrados, é considerada a maior ilha do mundo e possui uma população de aproximadamente 56 mil habitantes. Por sua localização estratégica e recursos naturais, a ilha tem sido alvo de interesse de diversos países, incluindo os Estados Unidos.
A declaração de Trump gerou surpresa e indignação em muitos países, especialmente na Dinamarca, que é a atual governante da Gronelândia. O primeiro-ministro dinamarquês, Mette Frederiksen, classificou a ideia como “absurda” e afirmou que a ilha não está à venda. Além disso, a declaração também foi criticada por políticos e especialistas em relações internacionais, que a consideraram uma tentativa de intimidação e desrespeitosa com a soberania de outro país.
No entanto, é importante analisar essa declaração de forma mais ampla e entender os possíveis motivos por trás dela. Desde o início de seu mandato, Trump tem adotado uma postura de “América Primeiro”, buscando sempre defender os interesses do seu país acima de qualquer outra coisa. Nesse contexto, a possibilidade de anexar a Gronelândia pode ser vista como uma forma de expandir o território e os recursos dos Estados Unidos.
Além disso, a ilha é estrategicamente importante para os Estados Unidos, principalmente em relação ao controle do Ártico. Com o aquecimento global, a região tem se tornado cada vez mais acessível e, consequentemente, a disputa por suas riquezas naturais tem se intensificado. A Gronelândia possui grandes reservas de petróleo, gás natural e minérios, o que a torna um alvo atraente para países que buscam garantir seu suprimento energético.
Outro fator que pode ter motivado a declaração de Trump é a crescente influência da China na região. O país asiático tem investido em projetos de infraestrutura e exploração de recursos naturais na Gronelândia, o que tem gerado preocupação nos Estados Unidos. Com a anexação, os americanos poderiam neutralizar essa influência e garantir sua posição como potência mundial.
É importante ressaltar que, apesar da declaração de Trump, a anexação da Gronelândia pelos Estados Unidos é algo extremamente improvável de acontecer. Além da resistência da Dinamarca, a própria população da ilha tem manifestado seu desejo de permanecer sob o controle do país europeu. Além disso, a comunidade internacional certamente se oporia a essa ação unilateral dos Estados Unidos.
No entanto, a declaração de Trump serve como um alerta para a importância da região do Ártico e para a necessidade de se discutir a soberania e a exploração de seus recursos de forma responsável e sustentável. É preciso que os países envolvidos busquem soluções pacíficas e colaborativas, em vez de alimentar conflitos e rivalidades.
Em resumo, a declaração de Trump sobre a anexação da Gronelândia pelos Estados Unidos pode ter sido motivada por interesses políticos e econômicos, mas é pouco provável que se torne realidade. O importante é que esse episódio sirva como um alerta para a necessidade de se discutir a região do Ártico de forma